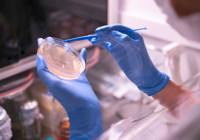
Nuvita İlaç, Türkiye Ar-Ge 250 listesinde ilk 250’ye girdi

Abdulkadir Selvi
Asgari ücret ve emekli maaşları ne olacak
Abdulkadir Selvi
Asgari ücret ve emekli maaşları ne olacak
 Ahmet Hakan
DEM’siz CHP
Ahmet Hakan
DEM’siz CHP
 Nedim Şener
Koyun postuna girmiş çakallar: Mossad, Barzani ve PKK/SDG
Nedim Şener
Koyun postuna girmiş çakallar: Mossad, Barzani ve PKK/SDG
 Yüksel Aytuğ
Bu gidiş nereyedir?
Yüksel Aytuğ
Bu gidiş nereyedir?
 Yavuz Donat
Mustafa Destici
Yavuz Donat
Mustafa Destici
 Yalçın Bayer
Bodrum’u mahvettik… Dünya markası iddiası güme gidiyor
Yalçın Bayer
Bodrum’u mahvettik… Dünya markası iddiası güme gidiyor
 İsmet Özçelik
AK Parti, CHP, Barrack’a neden ses çıkarmıyor
İsmet Özçelik
AK Parti, CHP, Barrack’a neden ses çıkarmıyor
 Ersin Çelik
Papa’nın arayışı: İslam’dan daha az korkmak…
Ersin Çelik
Papa’nın arayışı: İslam’dan daha az korkmak…
 Bülent Cankurt
Spagetti çantayla absürt gündem!
Bülent Cankurt
Spagetti çantayla absürt gündem!
 Akif Beki
Türkiye Yüzyılı okullarda zorbalığı niye durduramıyor?
Akif Beki
Türkiye Yüzyılı okullarda zorbalığı niye durduramıyor?
 Turgay Yerlikaya
Siyasetin özgürleşmesi: DEM’in sorumluluğu
Turgay Yerlikaya
Siyasetin özgürleşmesi: DEM’in sorumluluğu
 Tülin Türkoğlu
Kadın Konuşursa Türkiye Değişir
Tülin Türkoğlu
Kadın Konuşursa Türkiye Değişir
 Ömür Gedik
‘Zerhun’ 70 ülkede izlenecek
Ömür Gedik
‘Zerhun’ 70 ülkede izlenecek
 Ömer Lekesiz
Kendi zamanımızın sanatı hakkında başımızı ağrıtan kelimeler...
Ömer Lekesiz
Kendi zamanımızın sanatı hakkında başımızı ağrıtan kelimeler...
 İbrahim Karagül
Savaşı Karadeniz’e taşıyan kim?
Türk denizlerine taşıyanlar kim?
O...
İbrahim Karagül
Savaşı Karadeniz’e taşıyan kim?
Türk denizlerine taşıyanlar kim?
O...
 Gökhan Özcan
Arpacı kumruları
Gökhan Özcan
Arpacı kumruları
 Mustafa Balbay
Papanın ziyareti!
Mustafa Balbay
Papanın ziyareti!
 Mustafa Karaalioğlu
Özgür Özel’in ve CHP’nin siyasi portföyü
Mustafa Karaalioğlu
Özgür Özel’in ve CHP’nin siyasi portföyü
 Fatih Çekirge
Turizmde ‘yangın alarmı’
Fatih Çekirge
Turizmde ‘yangın alarmı’
 Barış Terkoğlu
200 günlük burun sürtme davası
Barış Terkoğlu
200 günlük burun sürtme davası
 Melih Aşık
Büyükelçi
Melih Aşık
Büyükelçi
 Ali Eyüboğlu
Le Figaro’daki Doğu Ekspresi
Ali Eyüboğlu
Le Figaro’daki Doğu Ekspresi
 Hakkı Öcal
Yine mi Amerika?
Hakkı Öcal
Yine mi Amerika?
 Mehmet Tezkan
Erdoğan 23 yıldır iktidarda mutlu mudur?
Mehmet Tezkan
Erdoğan 23 yıldır iktidarda mutlu mudur?
 Orhan Bursalı
Bir çıkmaz sokakta yeniden iktidar arayışı
Orhan Bursalı
Bir çıkmaz sokakta yeniden iktidar arayışı
 Osman Müftüoğlu
İhtiyarlamak şart mı
Osman Müftüoğlu
İhtiyarlamak şart mı
 Sedat Ergin
Hakan Fidan’ın Ahmed Şara’ya bakışı
Sedat Ergin
Hakan Fidan’ın Ahmed Şara’ya bakışı